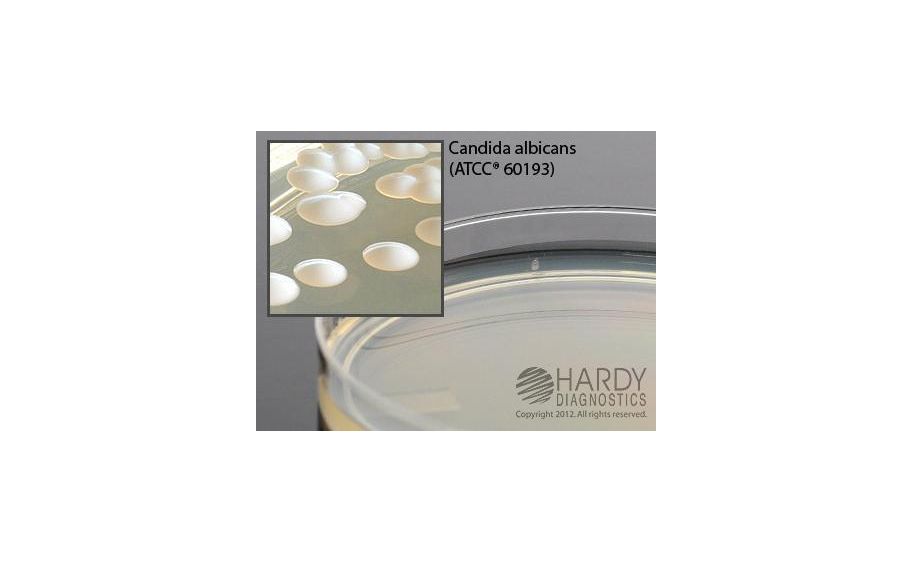
main product photo

Need Help?
800-229-7252

SABDEX (SABOURAUD DEXTROSE) AGAR PK10
1
/
PK
Lead Time
12 Day(s)
SKU
VWR52428-858-PK
MFRPN
W72
SABDEX (SABOURAUD DEXTROSE) AGAR PK10
Sabdex (Sabouraud Dextrose) Agar With Chloramphenicol Deep Fill, 15X100Mm Plate, Order By The Package Of 10, By Hardy Diagnostics
| Manufacturer | Hardy Diagnostics |
|---|---|
| MFRPN | W72 |
| Lead Time | 12 Day(s) |
| UNSPSC Code | 12000000 |
Write Your Own Review